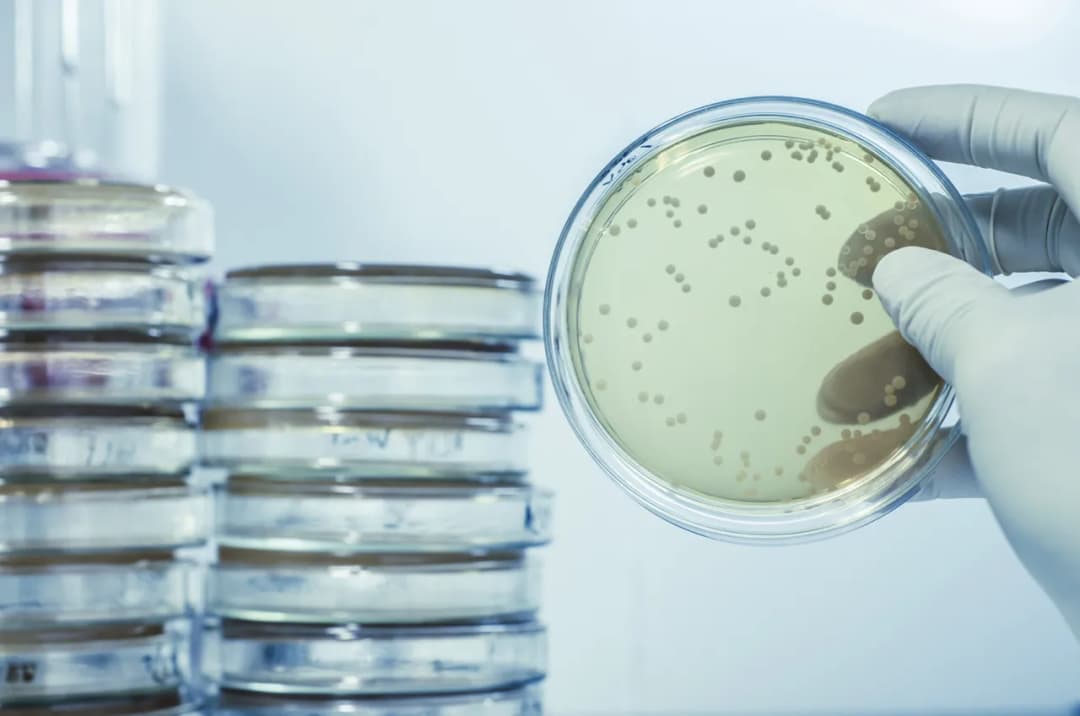
Częste infekcje u dziecka: jakie badania pomogą ustalić przyczynę?

Badania
Zastanawiasz się, jakie badania pomogą ustalić przyczyny częstych infekcji u dziecka? Sprawdź, które testy są kluczowe dla zdrowia Twojej pociechy.
Zastanawiasz się, jakie badania pomogą ustalić przyczyny częstych infekcji u dziecka? Sprawdź, które testy są kluczowe dla zdrowia Twojej pociechy.